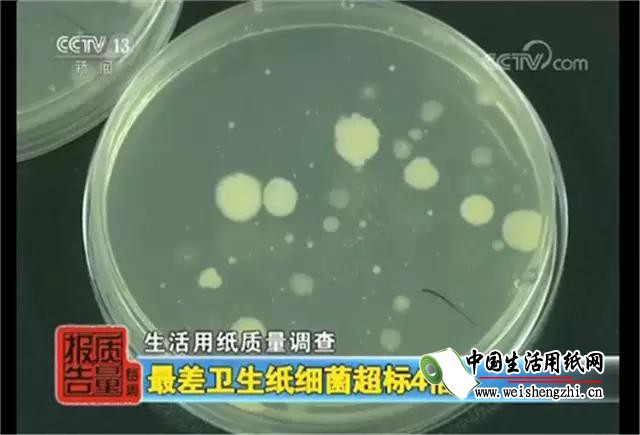

随着生活水平的提高,大家对生活用品的关注也越来越多,就连在选择卫生纸的时候,大家也一改以往不在乎的态度,变得越来越重视。

是什么改变了大家的态度?事实上,在很早之前,央视和各大卫视就陆续曝光了很多不良商家生产出来的劣质纸巾,让消费者们意识到——原来我们日常生活中经常使用的卫生纸,不一定卫生!

目前市面上的纸巾品牌五花八门,质量也参差不齐,只要稍不留神就会买到劣质的纸巾。而这些劣质纸巾潜藏的危害,会对我们的人体健康造成严重威胁。

为了健康着想,大家不得不重视卫生纸的品质,拒绝使用劣质卫生纸,远离可以避免的伤害。
那么,劣质卫生纸都具有哪几个特征?
1.颜色过白
有些厂家为了迎合消费者的心理,提高纸的白度,在生产中,一是使用荧光增白剂,而荧光增白剂是一种对人体具有严重危害的复合有机化合物;二是使用大量的漂白粉,造成纸的内部纤维被严重破坏。
2.加滑石粉
有的厂家为降低成本,在卫生纸生产过程中,加入了滑石粉,为了提高滑石粉的留着率,同时加入淀粉,造成卫生纸重量沉、外观体积小、价格便宜,但非常不好用。
3.有异味
有的厂家用劣质原料生产卫生纸,细菌严重超标,不得不使用大量化学药品进行消毒。但不论采用什么措施,也清除不掉纸中的异味,消费者使用以后,会引起多种疾病。
4.进行膨化
为了增加纸的体积,有些厂家像爆米花一样,在原料中加入大量膨化剂,生产的卫生纸体积特别大,给消费者造成一种假象——此种卫生纸数量多,又柔软。但是使用起来效果特别差!纸张拉力非常小,几乎没有吸水性。
不管是外出用纸,还是在家用纸,我们都要挑选一些品质有保证的卫生纸。







